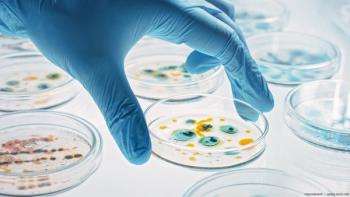
Gloved hand grabbing petri dish with bacteria Image credit: ©Gorodenkoff - adobe.stock.com

Catch up on what happened in optometry during the week of September 2-September 6.

Catch up on what happened in optometry during the week of September 2-September 6.

Resources available during the month include a seminar series and course bundles.

Young will be aiding in expanding real-world evidence programs to promotion the adoption of Brightstar’s BrightMEM corneal allograft for the treatment of limbal stem cell deficiency and persistent epithelial defects.

This year's theme, "Love Your Eyes," focuses on children's vision and eye health.

The new, non-diffractive IOLs are the second generation of BVI’s ISOPURE premium monofocal IOL that was launched in 2019.

According to the UK study, for every 0.5-diopter increase in mean spherical equivalent, a 6% higher risk was attributed in developing depressive disorders.


Catch up on what happened in optometry during the week of August 26-August 30.

AOA associate members have access to services, programs, educational materials, and discounts on event registration fees, according to a news release.

Injectsense's future plans for the sensor are to fine-tune its delivery tool and incorporate a microbattery into the sensor.

The strike force involves more than a dozen medical and nonmedical professionals to help bridge the gap between failed vision screenings and follow-up examinations.

With strabismus making headlines after Stephen Nedoroscik's performance at the 2024 Olympic Games, Dr. Lojka overviews the condition and how optometrists can care for athletes with eye conditions.

Catch up on what happened in optometry during the week of August 19-August 23.

The device features cross-polarized light technology, allowing for image clarity without the need for pupil dilation.
The alert follows a warning letter issued by US FDA to a company that manufacturers eye drops that claim to change eye color.

UPTE states that although UC's proposal has improved from previous proposals, it still "leaves a lot to be desired."

A research team for the $3.3 million study will assess the front and the back of the eye and different types of glucose dysfunction.

Catch up on what happened in optometry during the week of August 12-August 16.

The survey’s results were released by Bausch + Lomb last month and revealed that many participants did not know their symptoms were dry eye-related.

Both seasoned and newer practice owners share their insights for preventing burnout through practice management.

The study found that of Medicaid enrollees, 12% do not have coverage for routine adult eye exams and 27% are without coverage for eyeglasses.

Jack Chapman, MD, weighs in on the importance of nailing refraction on the first visit to the optometrist's office in the light adjustable lens fitting process after identifying the best candidate.

LNZ100 is an aceclidine-based ophthalmic solution and demonstrated statistically significant results in the Phase 3 CLARITY study.

Catch up on what happened in optometry during the week of August 5-August 9.

Not much changes in terms of postoperative care for cataract patients that opt for the LAL besides additional follow-up visits.

The new smart glasses utilize artificial intelligence to visually assist those with age-related macular degeneration and other retinal disorders causing vision loss.

Vevizye was approved by the US FDA under the name Vevye in May 2023 for the treatment of moderate to severe dry eye disease.

Catch up on what happened in optometry during the week of July 29-August 2.

A majority of the 1000 survey participants stated that they are concerned about the eye health of their children, particularly those between 4 and 9 years old.

The launch of the interactive vision curriculum kit series aligns with National Children’s Eye Health and Safety Month, which is recognized in August.